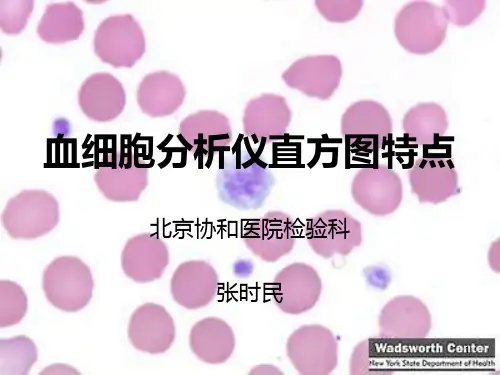

血常规血细胞分析仪直方图共87页文档
- 格式:ppt
- 大小:6.78 MB
- 文档页数:87


血细胞直方图核心提示:直方图是统计学上常用的来表示样本各组在成分布的一种直观的图表。
如图1所示:X轴表示体积单位,Y轴表示个数(即统计学的频数),柱条表示在某个体积段内的物体个数。
将体积段无限细分下去方块图就会变成曲线图。
图1 图2_S1表示的是常见血细胞分析仪的红细直方图是统计学上常用的来表示样本各组在成分布的一种直观的图表。
如图1所示:X轴表示体积单位,Y轴表示个数(即统计学的频数),柱条表示在某个体积段内的物体个数。
将体积段无限细分下去方块图就会变成曲线图。
图1图2_S1表示的是常见血细胞分析仪的红细胞直方图:曲线的每个点对应的坐标(X,Y)表示X体积的红细胞有Y个,而曲线与X轴围成的范围表示的是红细胞的总数。
图中显示了两个峰,A峰体积小,峰值是PLT(血小板)峰,B峰值高,显示RBC(红细胞)峰。
而A、B峰的面积显示了PLT和的RBC总量,峰值的X坐标显示了RBC和PLT体积大小,峰宽显示了RBC和PLT体积的极差(最大值和最小值之差).峰的面积越大表示总量越多,峰越宽表示体积大小差异越大,即大小分布不均。
曲线向左移(如S2),即表示,RBC和PLT的体积较小,曲线向右移,即表示,RBC和PLT的体积较大。
因此通过红细胞分布直方图,再结合Hb、MCH、MCVH等指标就能知道,是不是贫血,是大细胞正色素性贫血,还是小细胞低色素性贫血、以及大小分布状况等临床诊治信息。
图2同理,白细胞分布直方图(图3)也一样。
在图3_a中前一峰是淋巴细胞峰,后一峰是中性粒细胞峰,a1、a2显示了不同大小的粒细胞图。
具体分析同红细胞分布图。
图3直方图能很直观的看出血分析中的各类指标,但因为只能给人一个感性的认识,对于单独一张报告单,就很难知道这个分布是不是正常,因此有许多血细胞分析仪用了RDW(红细胞分布宽度)PDW (血小板分布宽度)等指标来反映直方图的信息,本人认为更贴合于临床。

解析血细胞分析仪直方图有些自动血细胞分析仪的报告单附带有细胞直方图,那么这些图有什么用,能提供什么临床的信息呢?在国内,大多数医师都不甚了了,一般都不看的,也看不懂。
在以前人工做的时代,在报告RBC、WBC、PLT、Hb等参数的时代,还附带了诸如:RBC 大小、分布等等形态学的报告,但进入自动化时代这些形态学的报告就不再出现在报告中了,因此许多医生很不习惯,总是要求做手工,但实际上在目前几乎所有的报告中都能出关于血细胞的一些形态特征,而细胞直方图就是其中的一种报告方式。
怎样解读细胞直方图呢?首先,我们要知道什么是直方图。
直方图是统计学上常用的来表示样本各组在成分布的一种直观的图表。
如图1所示:X轴表示体积单位,Y轴表示个数(即统计学的频数),柱条表示在某个体积段内的物体个数。
当我们将体积段无限细分下去方块图就会变成曲线图,如同我们的报告单上的一样。
图2_S1表示的是常见血细胞分析仪的红细胞直方图:曲线的每个点对应的坐标(X,Y)表示X体积的红细胞有Y个,而曲线与X轴围成的范围表示的是红细胞的总数(对于数学模型而言,就是曲线的定积分)。
图中显示了两个峰,A峰体积小,峰值也小是PLT(血小板)峰,B峰体积较在,峰值高,显示RBC(红细胞)峰。
而A、B峰的面积显示了RBC和PLT的总量,峰值的X坐标显示了RBC和PLT体积大小,峰宽显示了RBC和PLT体积的极差(极差可不是特别差^O^,而是统计学中常用来表示离散程度的指标,即一组观察值中,最大值和最小值之差)。
峰的面积越大表示总量越多,峰越宽表示体积大小差异越大,即大小分布不均。
曲线向左移(如S2),即表示,RBC和PLT的体积较小,曲线向右移,即表示,RBC和PLT的体积较大。
因此通过红细胞分布直方图,再结合Hb、MCH、MCVH等指标就能知道,是不是贫血,是大细胞正色素性贫血(缺铁?),还是小细胞低色素性贫血(缺叶酸?)、以及大小分布状况(地海贫?)等临床诊治信息。



